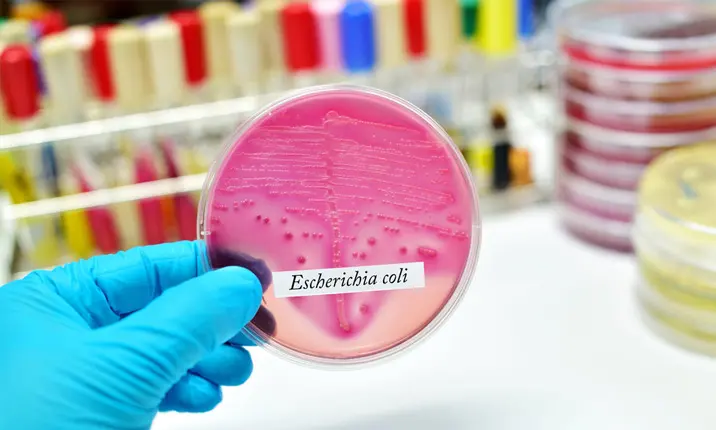

Source: Shutterstock
Prenatal Infections and How to Avoid Them
Last updated: Tuesday, March 5, 2019 | 6 min reading time
During pregnancy, taking care of yourself is the key to giving your baby the best possible start to life. Prenatal infections can interfere with the health of both you and your baby, so it's important to take steps to prevent them.
Pregnancy and general prenatal health
The 9-month gestational period is usually discussed in terms of 3 distinct trimesters. Each trimester is different in terms of the development of your baby and the likelihood of any risks, but in general the further you progress through your pregnancy, the less likely it is that you will encounter any serious complications. Eating a balanced diet, participating in regular non-strenuous exercise, and avoiding drugs, alcohol and smoking are all simple ways to maintain good health throughout each trimester. You can also talk to your doctor about any prenatal vitamins that they might recommend. As your baby depletes your resources of important minerals and nutrients, replenishing them with a supplement can help keep you healthy.
Prenatal infections
There are several types of infections that can be unsafe for both you and your baby if contracted during pregnancy. Some of these infections are usually considered low risk in adults, but become high risk when contracted by a pregnant woman. It's important to be aware of these infections and how to avoid them.
Zika virus
The Zika virus is a viral infection transmitted by the bite of an infected Aedes mosquito. Zika can also be sexually transmitted between humans, and transmitted directly from mother to foetus. Most people don't have any symptoms, but those who do may experience a fever, rash, conjunctivitis and joint pain.
In pregnancy, Zika is linked to the following foetal complications:
- Microcephaly (stunted head growth)
- Brain damage
- Miscarriage
- Stillbirth
Group B streptococcus (GBS)
GBS is a bacterium that normally lives in our bodies and usually causes no harm. However, if a woman carries these bacteria inside her vagina, there is a small risk that the baby could become infected during vaginal delivery. When baby becomes infected, the illness may be life-threatening. Preterm labour and delivery increases the severity of the illness.
Symptoms and complications for infected babies include:
- Fever, fatigue, breathing difficulties, blue-tinged skin
- Pneumonia
- Meningitis
- Sepsis (a blood infection)
Cytomegalovirus
Cytomegalovirus (CMV) is a form of the herpes virus that is very common among young children. Once infected, the virus will usually remain dormant within a person for the rest of their life. It is spread by bodily fluids, and in unborn children it can be contracted either from the dormant virus reactivating in the mother, or a new infection during the pregnancy.
The risk is highest during the first half of the pregnancy, and can result in:
- Permanent intellectual disabilities
- Developmental delays
- Hearing or vision loss
- Cerebral palsy
Listeriosis
Listeriosis is an infection caused by the bacteria listeria, which is found in the environment, in soil, water and in animals such as cows. When it's ingested by humans via contaminated food, the bacteria feed on human cells and cause listeriosis, which is particularly serious for infants and the elderly. It is believed that pregnant women become more susceptible as the pregnancy progresses.
Listeriosis can cause:
- Preterm birth
- Miscarriage
- Still birth
- Life-threatening illness
Escherichia coli (E. coli)
coli is a bacterium that can be found naturally in your vagina and gut. It is generally harmless but when passed from the mother's genital tract to the baby during childbirth, it may cause sudden infant death syndrome (SIDS) in newborns.
coli infection in a pregnant woman can affect your pregnancy by increasing various complications:
- Diarrhoea which results in loss of body fluids leading to dehydration
- In some rare cases, the pregnant woman may start to bleed heavily
- Preterm birth
- Miscarriage
- Low birth weight
Other common infections
There are many other infections that are common during pregnancy, but they are not always cause for major concern.
Yeast infections can be uncomfortable, but will not harm your baby.
It is also normal to contract a urinary tract infection (UTI) during pregnancy, particularly if you get them often anyway, but as long as you treat it and it doesn't develop into a kidney infection, your baby will be fine.
Sexually transmitted infections (STIs) are wide-ranging, and some are more serious than others, so if you think you might have contracted an STI, you should have it checked.
Even if you think you are fine, in the case of any illness or infection during pregnancy, it is always best to see your doctor.
Preventing infection
Apart from maintaining your overall health and keeping up with your regular prenatal appointments, you can take extra precautions to protect your unborn baby.
- As the Zika virus is often spread by mosquito bites, avoid travelling to areas with high mosquito populations. If you live in an area affected by Zika, or travel is unavoidable, try to avoid being bitten. Sleep under a mosquito net and stay away from large bodies of water where mosquitoes are more prevalent. If your partner travels to a Zika infected area, you may want to avoid sexual contact or use protective barrier methods if you have sexual intercourse during the pregnancy.
- There is no vaccine for Guillain Barré Syndrome (GBS) yet, but during your pregnancy you can take a test to find out if you are carrying the bacteria. If you are tested to be a carrier of GBS, you can take antibiotics during labour so that you don't pass the bacteria on to your baby. It is still important to monitor your baby after this, in case they develop a late-onset form of the infection.
- You can reduce your chance of exposure to CMV by washing your hands regularly, especially after coming in to contact with young children. Don't share saliva with young children via toothbrushes, kissing, or food and drinks. If you are a childcare worker constantly exposed to young children, you might want to talk to your doctor about CMV testing.
- Avoiding contaminated foods is the best way of preventing listeriosis. Some foods are considered high-risk for this reason, and during pregnancy most doctors recommend cutting them out of your diet completely. These include unpasteurised milk and dairy, deli meat and salad bars, meat spreads and pate, soft cheese, and soft serve ice cream. You should also wash all fruits and vegetables prepared at home.
- To avoid E. coli bacteria during pregnancy, make sure you clean your hands with a disinfectant after touching raw meat. Always wash your hands with soap after using or cleaning the toilet, handling linens or dirty towels, changing diapers and touching animals. This is because E. coli is found in urine and faecal matter.
A healthy pregnancy
Staying well throughout your pregnancy is something that your doctor and obstetrician will help you with. You can take steps to avoid infection, but the best thing you can do is look after yourself and your overall health. Although it can be an overwhelming time, keeping your stress levels low by getting regular checks will help you enjoy your pregnancy as much as possible.
Alli, R.A. (2017, May 18) Group B strep infections in babies and newborns. Retrieved 10/2/19 from https://www.webmd.com/parenting/baby/baby-group-b-strep#2-7
Bandukwala, N.Q. (2018, April 17) What if I get a UTI while I'm pregnant? Retrieved 10/2/19 from https://www.webmd.com/women/guide/pregnancy-urinary-tract-infection
Cytomegalovirus and pregnancy (2017, January 11) Retrieved 10/2/19 from https://www.health.nsw.gov.au/infectious/factsheets/Pages/cmv-and-pregnancy.aspx
Johnson, T.C. (2018, June 25) Yeast infection. Retrieved 10/2/19 from https://www.webmd.com/baby/yeast-infection
Johnson, T.C. (2017, November 13) Pregnancy and Sexually Transmitted Diseases. Retrieved 10/2/19 from https://www.webmd.com/baby/pregnancy-sexually-transmitted-diseases#3
Martin, L.J. (2011, September 29) Listeria: Are you at risk? Retrieved 10/2/19 from https://www.webmd.com/food-recipes/food-poisoning/news/20110929/listeria-are-you-at-risk#3
Prevent Infections During Pregnancy (2018, June 18). Retrieved 10/2/19 from https://www.cdc.gov/features/prenatalinfections/index.html
Robinson, J. (2018, October 23) Zika Virus: What You Should Know. Retrieved 10/2/19 from https://www.webmd.com/a-to-z-guides/zika-virus-symptoms-prevention
Group B Streptococcus (GBS) in pregnancy and newborn and babies. Retrieved on 26/02/19 from https://www.rcog.org.uk/globalassets/documents/patients/patient-information-leaflets/pregnancy/pi-gbs-pregnancy-newborn.pdf
Bandukwala, N.Q. (2018, April 17) What if I get a UTI while I'm pregnant? Retrieved 10/2/19 from https://www.webmd.com/women/guide/pregnancy-urinary-tract-infection
Cytomegalovirus and pregnancy (2017, January 11) Retrieved 10/2/19 from https://www.health.nsw.gov.au/infectious/factsheets/Pages/cmv-and-pregnancy.aspx
Johnson, T.C. (2018, June 25) Yeast infection. Retrieved 10/2/19 from https://www.webmd.com/baby/yeast-infection
Johnson, T.C. (2017, November 13) Pregnancy and Sexually Transmitted Diseases. Retrieved 10/2/19 from https://www.webmd.com/baby/pregnancy-sexually-transmitted-diseases#3
Martin, L.J. (2011, September 29) Listeria: Are you at risk? Retrieved 10/2/19 from https://www.webmd.com/food-recipes/food-poisoning/news/20110929/listeria-are-you-at-risk#3
Prevent Infections During Pregnancy (2018, June 18). Retrieved 10/2/19 from https://www.cdc.gov/features/prenatalinfections/index.html
Robinson, J. (2018, October 23) Zika Virus: What You Should Know. Retrieved 10/2/19 from https://www.webmd.com/a-to-z-guides/zika-virus-symptoms-prevention
Group B Streptococcus (GBS) in pregnancy and newborn and babies. Retrieved on 26/02/19 from https://www.rcog.org.uk/globalassets/documents/patients/patient-information-leaflets/pregnancy/pi-gbs-pregnancy-newborn.pdf
 Brain & Spine Care
Brain & Spine Care